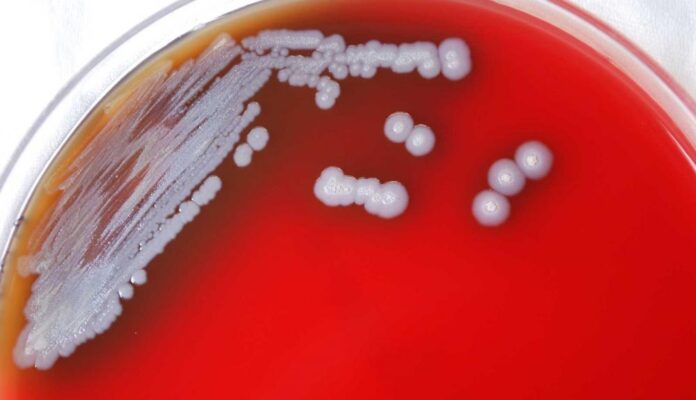

This piece examines the little-publicized Category B bioterrorism agent Burkholderia pseudomallei and the disease of melioidosis. Of particular concern are the recent 21st century melioidosis outbreaks that have occurred in the United Sates where only imported melioidosis cases had previously been reported, and endemic melioidosis was unknown. Further, the accidental contamination of an aromatherapy spray that sickened four people and caused two deaths brings to light the bioterrorism potential of this disease.
What is Mellioidosis?
Melioidosis is a disease of concern caused by the bacteria Burkholderia pseudomallei. Melioidosis and its causative agent are considered Category B bioterrorism diseases by the US Centers for Disease Control and Prevention (CDC). These are among the second highest priority agents and diseases having bioterrorism potential. The CDC considers Category B pathogens and diseases to be moderately easy to disseminate, resulting in moderate morbidity and low mortality, and requiring specific enhancements of the CDC’s diagnostic capacity and enhanced disease surveillance for detection and diagnosis.
B. pseudomallei is also on the US Health and Human Services (HHS) and US Department of Agriculture (USDA) Select Agents and Toxins List. Yet many working in public health would likely have difficulty describing the disease and its causative agent.